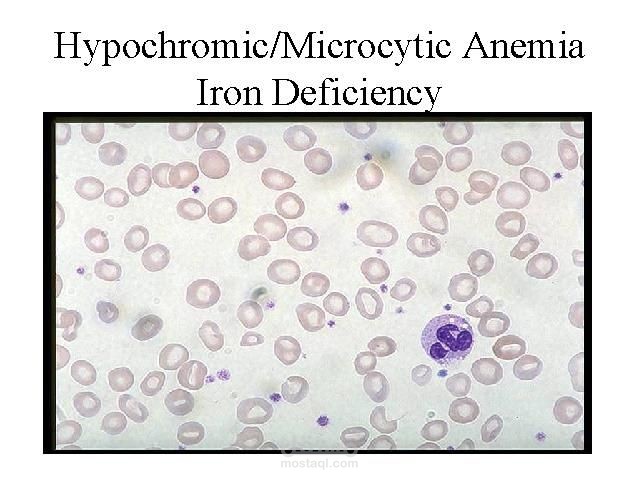
Microcytic Anemia Case Study – CBC Report Interpretation

Dalia H.
نبذة عني
Medical content writer specializing in short educational scripts and simplified explanations of lab tests and medical concepts.
I provide clear, accurate, and well-structured content for medical pages, students, and training centers.
Fast delivery and high quality
I’m new to freelancing but I’m passionate about medical education and content creation.
I’m focused on accuracy, clarity, and simplicity.
Created educational medical videos on social media (CBC, anemia, blood indices).
مهاراتي
التقييمات
5.0
5.0
5.0
5.0
5.0
5.0